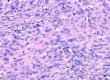

犬貓皮膚常見的一種間葉組織 (mesenchymal origin)來源腫瘤,分類上為軟組織間葉性腫瘤(soft tissue mesenchymal tumors, STMTs)的一種。
這個分類的腫瘤還包含了其它數種臨床常見的腫瘤,如週邊神經髓鞘瘤(peripheral nerve sheath tumor, #PNST)、惡性纖維肉瘤(fibrosarcoma)及惡性脂肪肉瘤(liposarcoma)等等。
此類種瘤的一個特徵,就是在動物四肢或軀幹出現極大型的腫塊,但不一定會有表皮潰瘍。
STMTs腫瘤的組織學惡性程度分級會依據腫瘤細胞的分化程度(differentiation score)、有絲分裂相(mitotic count)、壞色組織面積(necrosis area)進行評分。一般以第2級(grade 2),中度惡性的腫瘤較為常見,具有一定程度的術後復發機率及轉移機率。